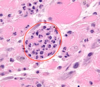

Pathoma Cardiac Pathology Flashcards
(37 cards)
Three subtype of angina and what each is all about
1. Stable Angina: CP that arises with exertion or emotional stress. >70% stenosis. REVERSIBLE injury to myocytes w/o necrosis. Lasts <20 min. ST depression. Tx: rest, nitro
2. Unstable Angina: CP that occurs at rest. Due to rupture of atherosclerotic plaque with thrombosis and INCOMPLETE occlusion of coronary artery. REVERSIBLE injury. ST depression. High risk to progress to MI. Tx: nitro
3. Prinzmetal Angina: episodic CP unrelated to exertion. REVERSIBLE injury. Due to coronary artery vasospasm. ST elevation due to transmural ischemia. Tx: nitro, CCB
Myocardial Infarction and what are 3 most common arteries involved
- Necrosis of cardiac myocyte.
- Due to rupture of atherosclerotic plaque with thrombosis and COMPLETE occlusion of a coronary artery.
1. Left anterior descending artery (LAD) –>anterior wall and anterior septum (45% of cases)
2. Right Coronary Artery (RCA) –> posterior wall, posterior septum, papillary muscles LV (2nd most common)
3. Left Circumflex Artery (LCA) –> infarction lateral wall of LV
Treatment of MI
- ASA w/ w/o heparin, limits thrombosis
- O2 to minimize ischemia
- Nitrates: vasodilate veins* and coronary arteries
- B-blocker: slow HR, decrease demand of heart
- ACE-I: decrease blood volume, decrease TPR
- fibrinolytics (tPA) or angioplasty (stent)
Two complications after angioplasty of coronary vessels after an acute MI
1. Contraction band necrosis: reperfusion leads to an influx of calcium, leading to hypercontraction of myofibrils (despite cell being dead with no nucleus)
2. Reperfusion injury: return of O2 and inflammatory cells may lead to free radical generation. (often see an additional increase in troponin after angioplasty due to formation of free radicals)

<4 hours after MI
- NO gross changes, NO microscopic changes
- Can see cardiogenic shock (massive infarction), CHF, arrhythmia
4-24 hours post MI
-Dark Discoloration
-Coagulative necrosis
-Complication of arrhythmia

1-3 days post MI
-Yellow pallor
-Neutrophils due to Acute Inflammation
-Complication of fibrinous pericarditis that presents as CP with friction rub
4-7 days post MI
- Yellow pallor
- macrophages present that are eatingup necrotic debris.
Risk of rupture of ventricular free wall HIGHEST now can lead to cardiac tamponade. Risk of rupture of interventricular septum leading to shunt, rupture of papillary muscle leading to mitral insufficiency (esp if RCA infarct)

1-3 months post MI
and Months after MI
1-3 months
- Red border emerges as grnaulation tissue enters from edge of infarct
- Granulation tissue with plump fibroblasts, collagen (type 1 Collagen), and blood vessels
Months
White scar, with fibrosis, risk of aneuysm, mural thrombus or Dressler syndrome (Ab against pericardium)

Causes of left sided HF
- Ischemia
- hypertension
- dilated cardiomyopathy
- MI
- Restrictive cardiomyopathy
Clinical features of left sided HF
-pulm congestion leading to pulmonary edema
-dyspnea, paroxysmal nocturnal dyspnea (due to increased venous return when lying flat), orthopnea, crackles
- Small congested capillaries burst, leading to intraalveolar hemorrhage marked by hemosiderin-laden macrophages
- decreased blood flow to kidneys resulting in activation of RAAS
-tx: ACE-I

Right sided heart failure causes and presentation
Causes: left sided heart failure, left to right shunt, cor pulmonale
Clinical: JVD, hepatosplenomegaly (with nutmeg liver) leading to cardiac cirrhosis, pitting edema (due to increased hydrostatic pressure)

Right sided HF vs Left sided HF

Ventricular Septal Defect (VSD)
-Defect in septum that divides right and left ventricles.
-most common congenital heart defect
L–> R shunt
Can result in Eisenmenger syndrome (reversal of shunt)
Tx: surgical closure
Associated with fetal alcohol syndrome****, Cri-du-chat syndrome

Atrial Septal Defect
-Most common type is ostium secundum (90% of cases)
-Ostium primum type is associated with Down Syndrome
-Results in L –> R shunt, split S2 on auscultation due to increased blood in right heart delays closure of pulmonary valve
-Paradoxical emboli can occur (instead of going to lung to cause PE, go to left side of circulation, end up going to brain or other circulation places)
-Distinct from patent foramen ovale in that septa are missing tissue rather than unfused.

Patent Ductus Arteriosus (PDA)
- Failure of ductus arteriosus to close
- Associated with congenital rubella
- Left –> Right shunt between aorta and pulm artery resulting in pulm HTN
-Machine-like murmur
-May lead to Eisenmenger syndrome, resulting in lower extremity cyanosis (because past branch point of aorta)
Tx: Indomethacin (decreases PGE). PGE KEEEEPS PDA open

Tetralogy of Fallot
1. Stenosis of right ventricular outflow tract
2. right ventricular hypertrophy
3. VSD
4. Aorta that overrides the VSD
-Right –> Left shunt
-pts learn to squat, increases arterial resistance by decreasing shunting and allowing more blood to reach lungs
-Boot shaped heart on X-ray

Transposition of great vessels associated with what and treated with what?
-Maternal diabetes
- presents with early cyanosis
- Need to create a shunt after birth, give PGE to keeeep PDA patent until surgery can be performed
Coarctation of Aorta
-Narrowing of the aorta. Two types
1. Infantile: associated with PDA, coarctation distal to aortic arch but proximal to PDA. Lower extremity cyanosis. Associated with Turner Syndome
2. Adult: not associated with PDA. Hypertension in upper extremities and weak pulses in lower extremities. Collateral ciruclation develops across intercostal arteries, engorged arteries cause “notching of ribs”Associated with Bicuspid Aortic Valve

Cause of acute rheumatic fever
2-3 weeks post Group A beta hemolytic streptococi
Caused by molecular mimicry, bacterial M protein resembles proteins in human tissue
3 types of pancarditis in Acute Rheumatic Fever
1. Endocarditis: Mitral valve > Aortic valve. Small vegetations along lines of closure that lead to regurgitation
2. Myocarditis: Aschoff bodies that are characterized by foci of chronic inflammation, reactive histiocytes with slender wavy nuclei (Anitschkow cells) MOST common cause of death
3. Pericarditis: leads to friction rub and CP

Aortic Stenosis
Systolic Murmur
Usually due to fibrosis and calcification. Increased risk with bicuspid aortic valve
-May also arise as a consequence of Chronic Rheumatic Valve Disease, coexisting mitral stenosis and fusion of the aortic valve commissures.
-Systolic ejection click followed by crescendo-decrescendo
-Concentric LVH, angina and syncope with exercise, microangiopathic hemolytic anemia (RBC damaged produces schistocytes)
Aortic Regurgitation
Diastolic Murmur
-Due to aortic root dilation (syphilitic aneurysm and aortic dissection), or valve damage (infectious endocarditis)
-Early blowing diastolic murmur
-Wide pulse pressure (increased systolic, decreased diastolic)
-Bounding pulse (water-hammer pulse), pulsating nail bed, head bob
-Eccentric hypertrophy (due to volume overload)
Concentric vs eccentric LV hypertrophy
Concentric: Aortic Stenosis, Hypertrophic Cardiomyopathy. Sarcomeres added in PARALLEL
Eccentric: Aortic Regurgitation, Dilated Cardiomyopathy. Sarcomeres added in SERIES





